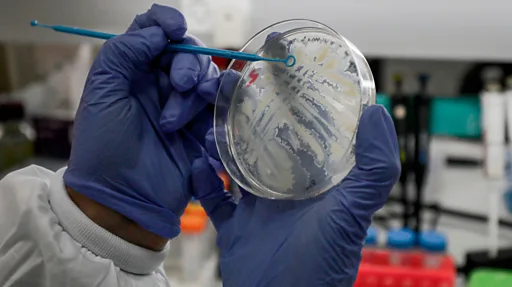

कोरोना वायरस: तीसरे चरण के संक्रमण से बचने के लिए कितना तैयार है भारत

इमेज स्रोत, Sandeep Rasal/SOPA Images/LightRocket/Getty Images
- Author, सरोज सिंह
- पदनाम, बीबीसी संवाददाता
इंडियन काउंसिल ऑफ़ मेडिकल रिसर्च के मुताबिक कोरोना वायरस का संक्रमण भारत में दूसरे स्तर पर है.
मतलब ये कि फ़िलहाल संक्रमण उन्हीं लोगों तक फैला है जो संक्रमण वाले देशों से भारत आए या फिर उन लोगों में फैला जो संक्रमित लोगों के संपर्क में आए.
महामारी के चार चरण
आईसीएमआर के अनुसार कोरोना वायरस फैलने के चार चरण हैं.
पहले चरण में वे लोग कोरोना वायरस से संक्रमित पाए गए जो दूसरे देश से संक्रमित होकर भारत में आए.
यह स्टेज भारत पार कर चुका है क्योंकि ऐसे लोगों से भारत में स्थानीय स्तर पर संक्रमण फैल चुका है.

इमेज स्रोत, Getty Images
दूसरे चरण में स्थानीय स्तर पर संक्रमण फैलता है, लेकिन ये वे लोग होते हैं जो किसी ना किसी ऐसे संक्रमित शख़्स के संपर्क में आए जो विदेश यात्रा करके लौटे थे.
तीसरा और थोड़ा ख़तरनाक स्तर है 'कम्युनिटी ट्रांसमिशन' का, जिसे लेकर भारत सरकार चिंतित है.
कम्युनिटी ट्रांसमिशन तब होता है जब कोई व्यक्ति किसी ज्ञात संक्रमित व्यक्ति के संपर्क में आए बिना या वायरस से संक्रमित देश की यात्रा किए बिना ही इसका शिकार हो जाता है.
पिछले दो सप्ताह में जितनी बार भारत सरकार के वरिष्ठ अधिकारियों ने प्रेस वार्ता की है, उसमें इस बात पर विशेष ज़ोर दिया गया है कि भारत में अभी तीसरा चरण नहीं आया है.
और चौथा चरण होता है, जब संक्रमण स्थानीय स्तर पर महामारी का रूप ले लेता है.

- कोरोना महामारी, देश-दुनिया सतर्क
- कोरोना वायरस के क्या हैं लक्षण और कैसे कर सकते हैं बचाव
- कोरोना वायरस का बढ़ता ख़तरा, कैसे करें बचाव
- कोरोना वायरस से बचने के लिए मास्क पहनना क्यों ज़रूरी है?
- कोरोना: मास्क और सेनेटाइज़र अचानक कहां चले गए?
- अंडे, चिकन खाने से फैलेगा कोरोना वायरस?
- कोरोना वायरस: बच्चों को कोविड-19 के बारे में कैसे बताएं?
- कोरोना वायरस: संक्रमण के बाद बचने की कितनी संभावना है
- कोरोना वायरस का कहर बरपा तो संभल पाएगा भारत?

तीसरे चरण यानी कम्युनिटी ट्रांसमिशन से निपटने के लिए कितना तैयार है भारत?
कोरोना वायरस से निपटने के लिए भारत के प्रयासों की सराहना विश्व स्वास्थ्य संगठन भी कर चुका है.
जब ये बीमारी चीन तक ही सीमित थी, तब ही WHO की रिजनल डायरेक्ट, साउथ इस्ट एशिया, पूनम खेत्रपाल सिंह ने स्वास्थ्य मंत्री को तीन चिट्ठियों के ज़रिए आगाह किया था.
विश्व स्वास्थ्य संगठन ने चिट्ठी में कोरोना से निपटने के लिए क्या ज़रूरी क़दम हर देश को उठाने चाहिए उसका भी ज़िक्र किया था.
उसी दिशा निर्देश का पालन करते हुए भारत सरकार के ना सिर्फ़ स्वास्थ्य मंत्रालय ने काम शुरू किया बल्कि केन्द्र सरकार ने इसके लिए ग्रुप ऑफ मिनिस्टर्स का भी गठन किया.
टेस्टिंग की सुविधा
माना जा रहा है कि तीसरे चरण में कोरोना संक्रमित लोगों की संख्या इतनी बढ़ जाएगी कि भारत के पास जितने लैब हैं उनमें सभी लोगों के टेस्ट पूरे नहीं किए जा सकते.
फिलहाल भारत सरकार के अनुसार देश में 70 से ज़्यादा टेस्टिंग यूनिट हैं जो आईसीएमआर के अंतर्गत काम कर रहे हैं.
आईसीएमआर के महानिदेशक डॉक्टर बलराम भार्गव के मुताबिक़ इस हफ़्ते के अंत तक क़रीब 50 और सरकारी लैब कोविड-19 की जाँच के लिए शुरू होंगे. कोविड-19 की जाँच के लिए भारत ने विश्व स्वास्थ्य संगठन से क़रीब दस लाख किट और माँगी हैं.
आईसीएमआर ने यह भी दावा किया है कि 23 मार्च तक भारत में दो ऐसे लैब तैयार हो जाएंगे जहाँ 1400 टेस्ट रोज़ हो सकेंगे. इससे तीन घंटे के भीतर कोविड-19 की जाँच की जा सकेगी.
इस तरह की कुछ अन्य मशीनें भी भारत सरकार ने विदेश से मंगवाई हैं. अमरीका और जापान के पास इस तरह की मशीने हैं जिनसे एक घंटे में कोविड-19 की जाँच की जा सकती है.
प्राइवेट लैब की तैयारी
भारत अगर कोरोना संक्रमण के तीसरे चरण में पहुंचता है तो ऐसा माना जा रहा है कि इस स्थिति से निपटने के लिए प्राइवेट लैब में भी कोरोना के जांच की ज़रूरत पड़ेगी.
आईसीएमआर के महानिदेशक डॉक्टर बलराम भार्गव के मुताबिक़ पिछले दिनों प्राइवेट लैब्स ने ऐसी इच्छा जताई है कि वो कोरोना संक्रमण के तीसरे चरण में सरकार के साथ मिल कर काम करना चाहते हैं.
लेकिन इस जांच के लिए किट की उन्हें जरूरत पड़ेगी. जो लैब्स सरकार के साथ संपर्क में हैं उनमें से एक हैं डॉ. अरविंद लाल, लाल पैथ लैब के मालिक.
उनके मुताबिक़ सरकार से बातचीत चल रही है कि एक टेस्ट पर कितना ख़र्च आएगा, प्राइवेट लैब इसके लिए लोगों से पैसा लेगी या सरकार उन्हें इस जांच के लिए मुफ़्त में किट मुहैया कराएगी. लेकिन इतना तय है कि सरकार प्राइवेट लैब्स के साथ इस विषय पर बातचीत कर रही है.
इस बारे में आईसीएमआर की बातचीत कुछ NABL सर्टिफाइड लैब के साथ चल रही है. सरकार ने इस बारे में दिशा निर्देश भी जारी किए हैं कि अगर किसी प्राइवेट अस्पताल या लैब में ऐसे संक्रमित व्यक्ति की पहचान होती है तो उसकी रिपोर्ट तुंरत सरकार के रजिस्टर्ड नंबर पर दिया जाए.
फंड की व्यवस्था
कोरोना वायरस का संक्रमण लोगों में कितना फैल रहा है, इसके लिए रोज़ाना सैंकडों की संख्या में संदिग्ध लोगों के टेस्ट कराए जा रहे हैं.
कोरोना संक्रमण पता करने के लिए दो तरह के जांच की ज़रूरत पड़ती है.
पहला बार में जिनका टेस्ट रिजल्ट पॉजिटिव आता है उन्हीं को दूसरे स्तर के लिए जांचा जाता है. दोनों स्तर के जांच के लिए
सरकारी आंकड़ों के मुताबिक़ एक टेस्ट पर 3000 रुपये का ख़र्च आता है. पहले स्तर के लिए 1500 रुपये तक का ख़र्च आता है.
इसके आलावा हज़ारों लोगों के टेस्ट पिछले कई दिनों में हो चुके हैं. फिलहाल इसका सारा ख़र्च केंद्र सरकार ही उठा रही है.
प्रधानमंत्री ने हाल ही में सार्क देशों के साथ वीडियो कांफ्रेंसिंग के ज़रिए जब चर्चा की थी, तो भारत की तरफ से 10 मिलियन डॉलर के कोरोना फंड की शुरूआत की बात भी कही थी.

इमेज स्रोत, Pramod Thakur/ Hindustan Times via Getty Images
सरकारी दिशा-निर्देश
चाहे स्कूलों में छुट्टियां करने की बात हो या फिर विदेश जाने और आने पर पाबंदी लगाने की बात हो, समय-समय पर सरकार ने इन सबके लिए ज़रूरी दिशा-निर्देश जारी कर जानकारी दी और पर्याप्त मात्रा में प्रचार प्रसार भी किया.
सरकार ने प्रचार में बॉलीवुड के स्टार अमिताभ बच्चन को भी उतारा है. ख़ुद स्वास्थ्य मंत्री डॉक्टर हर्षवर्धन #safehand चैलेंज में हिस्सा ले रहे हैं और वीडियो भी पोस्ट कर रहे हैं.
सरकार की इस तरह की पहल से लोगों में जागरूकता बढ़ी है और लोग सावधानी बरतने लगे है. इतना ही नहीं जब बाज़ार में सैनिटाइज़र और मास्क की कमी की खबरें आई तो सरकार ने तुरंत इसे ज़रूरी सामान की लिस्ट में डाल दिया ताकि इसकी कालाबाज़ारी रोकी जा सके.
कोरोना मामलों की बढ़ती संख्या को देखते हुए सरकार ने हेल्प लाइन के साथ-साथ जरूरी टोल फ्री नंबर भी जारी किया है. सोशल डिस्टेंसिंग के लिए किया करें क्या ना करें इस पर गाइडलाइंस जारी किए है.
सरकार के मुताबिक वो राज्य सरकारों से लगातार संपर्क में हैं और हर दिन प्रेस कांफ्रेंस कर मीडिया को भी इसके लिए अपडेट कर रही है.

इमेज स्रोत, Pratik Chorge/Hindustan Times via Getty Images
कोरोना के लिए GOM
भारत सरकार ने कोरोना वायरस के ख़तरे को भांपते हुए सबसे पहले स्थिति का जायज़ा लेने के लिए ग्रुप ऑफ मिनिस्टर्स (जीओएम) बनाया.
केंद्रीय स्वास्थ्य मंत्री डॉक्टर हर्षवर्धन की अध्यक्षता में गठित इस ग्रुप ऑफ मिनिस्टर्स में शामिल हैं - केंद्रीय नागरिक उड्डयन मंत्री हरदीप पुरी , केंद्रीय विदेश मंत्री एस जयशंकर, जहाजरानी मंत्री मनसुख मंडवाडिया, गृह राज्य मंत्री नित्यानंद राय, और स्वास्थ्य विभाग के राज्य मंत्री अश्विनी कुमार चौबे.
जीओएम की पहली बैठक 3 फरवरी को पहली बार हुई थी. इस बैठक में सभी संबंधित मंत्रालयों के सचिव भी शामिल हुए.
इस बैठक में केरल में पाए गए कोरोना वायरस के सबसे पहले मामले पर चर्चा हुई और आगे भारत को इस दिशा में क्या काम करना है इसका भी जिक्र हुआ.
ये जीओएम एक निश्चित अंतराल पर मिल कर लगातार स्थिति का जायज़ा लेती रहती है.
इस लेख में Google YouTube से मिली सामग्री शामिल है. कुछ भी लोड होने से पहले हम आपकी इजाज़त मांगते हैं क्योंकि उनमें कुकीज़ और दूसरी तकनीकों का इस्तेमाल किया गया हो सकता है. आप स्वीकार करने से पहले Google YouTube cookie policy और को पढ़ना चाहेंगे. इस सामग्री को देखने के लिए 'अनुमति देंऔर जारी रखें' को चुनें.
पोस्ट YouTube समाप्त, 1
इस लेख में Google YouTube से मिली सामग्री शामिल है. कुछ भी लोड होने से पहले हम आपकी इजाज़त मांगते हैं क्योंकि उनमें कुकीज़ और दूसरी तकनीकों का इस्तेमाल किया गया हो सकता है. आप स्वीकार करने से पहले Google YouTube cookie policy और को पढ़ना चाहेंगे. इस सामग्री को देखने के लिए 'अनुमति देंऔर जारी रखें' को चुनें.
पोस्ट YouTube समाप्त, 2

इमेज स्रोत, MohFW, GoI

(बीबीसी हिन्दी के एंड्रॉएड ऐप के लिए आप यहां क्लिक कर सकते हैं. आप हमें फ़ेसबुक, ट्विटर, इंस्टाग्राम और यूट्यूब पर फ़ॉलो भी कर सकते हैं.)